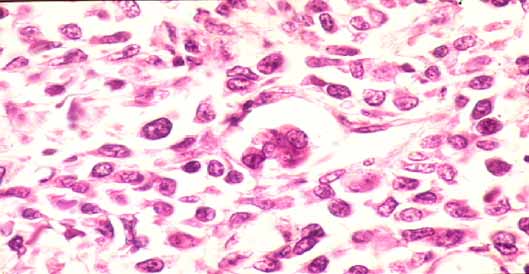
fig. 2

ComunicaciÛn
N∫ 042
ComunicaciÛn |
Fern·ndez R, Castellanos R, Pisani P, Almeida E, Rond·n M, LÛpez G, Otero M, Pizzarosa C.
 |
| FOTO 1. EpiplÛn mayor con numerosos nÛdulos tumorales de hasta 2 cm de di·metro, algunos con umbilicaciÛn central. |
|
| FOTO 2. MicroscopÌa tumoral observ·ndose detalles celulares. (HE 400x). |
 |
| FOTO 3. TÈcnica de Factor VIII. (40x) |
 |
| Gr·fico 1. Edad de presentaciÛn |
 |
| Gr·fico 2. Incidencia por sexo |